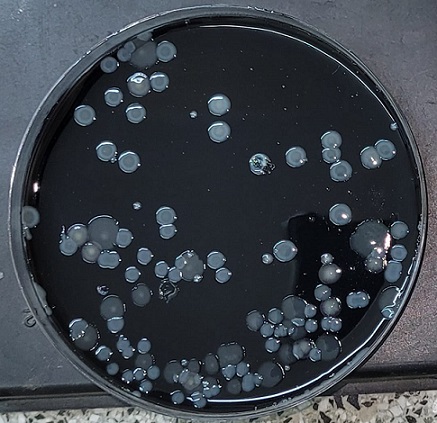

Información General | El Ministerio de Salud Pública a través de la Dirección de Inmunizaciones, continúa con la Campaña Antigripal 2022 para la población que se encuentra dentro del grupo de riesgo, mientras que sigue la aplicación de la vacuna contra el Covid-19. Además, esta semana la campaña Salud va a tu casa continúa en los barrios 9 de Julio y República de Venezuela de Capital.
.jpg)
Información General | El informe epidemiológico de la provincia de Corrientes registró este viernes, 7 nuevos casos positivos de Coronavirus, de los cuales 4 fueron contagios en la ciudad Capital y los 3 restantes en 2 localidades del interior provincial, al haberse analizado 708 muestras en las últimas 24 horas.

Información General | La elaboración está a cargo de agentes comunales pertenecientes al Obrador 3 y la primera tanda estuvo destinada a la ejecución de las veredas inclusivas de la plaza del barrio Industrial.

Información General | Se trata de un narcotest que contribuirá a la seguridad vial, indicó la Comuna.

Información General | Se trata de las obras del "Nuevo Puerto de la Ciudad de Corrientes" y el "Nuevo Puerto de Lavalle", localizados en la margen izquierda del río Paraná.

Información General | El informe epidemiológico de la provincia de Corrientes registró este jueves, 7 nuevos casos positivos de Coronavirus, de los cuales 1 fueron contagios en la ciudad Capital y los 6 restantes en 6 localidades del interior provincial, al haberse analizado 798 muestras en las últimas 24 horas.

Información General | El público decidió quién continúa en La Voz Argentina y Damián Ayala no fue de los elegidos para continuar en el certamen. El correntino interpretó Oración del remanso y su coach Soledad Pastorutti lo definió como la voz de la gente.

Información General | Como parte del Mes de la Juventud, la Municipalidad de la ciudad de Corrientes ofrecerá un abanico de propuestas gratuitas para disfrutar este fin de semana. Habrá patio gastronómico, intervenciones artísticas, festival chamamecero, actividades deportivas y acompañará al festival de rock organizado por el Gobierno de la provincia.
.jpg)
Información General | Con el objeto de complementar y optimizar los cambios en la circulación de la avenida Independencia y sus cruces con las calles Medrano, Río Juramento y Las Piedras, por directivas del Gobernador Gustavo Valdés, el Gobierno Provincial pavimentará con hormigón armado, dos cuadras de la calle Luis Braille.

Información General | Ayer por mañana apareció un puma en el patio de una casa en la localidad correntina de Mariano I. Loza. Éste fue capturado por policías e integrantes del Centro Aguará. Tras corroborarse que se encontraba en buenas condiciones, fue liberado en el Parque Iberá.

Información General | Después de que el rapero la fuera a ver al Movistar Arena a fines de agosto, muchos los vincularon sentimentalmente.

Información General | El informe epidemiológico de la provincia de Corrientes registró este miércoles, 13 nuevos casos positivos de Coronavirus, de los cuales 5 fueron contagios en la ciudad Capital y los 8 restantes en 5 localidades del interior provincial, al haberse analizado 891 muestras en las últimas 24 horas.

Información General | El presidente del Instituto de Cultura, Gabriel Romero, habló sobre el avance en los preparativos para el Taragüi Rock y el armado de la estructura dispuesta para el evento musical mas importante de la región.

Información General | Este miércoles alumnos de la Escuela Regional de Agricultura, Ganadería e Industrias Afines (ERAGIA) visitaron Casa de Gobierno como parte de recorrido por distintos edificios públicos que incluyó también a la Legislatura. Los chicos cursan el 3° año y varios de ellos no conocían estos lugares porque son del interior, así que es un paseo muy fructífero, explicó una de las docentes a cargo.
Información General | Gran preocupación generó en las últimas semanas la aparición de casos de una desconocida enfermedad causada por bacterias en la provincia de Tucumán, que pudo ser identificada como Legionella. Desde el año 2014 el Instituto de Medicina Regional de la UNNE viene estudiando esta patología emergente y alertando respecto a la importancia de realizar estudios epidemiológicos e implementar medidas preventivas.
Página 218 de 1829




